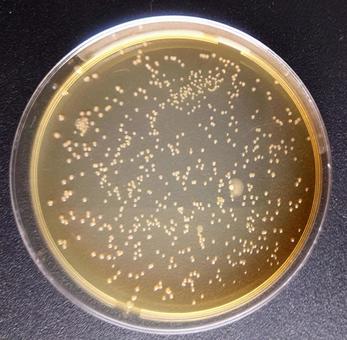
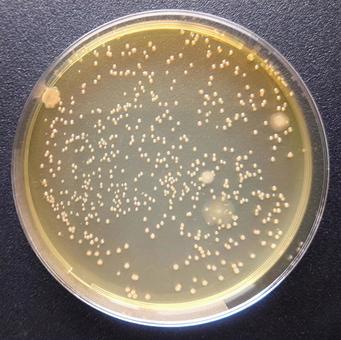

New
New






























全3,545件中841 - 910件
「化学実験」のキーワードで新規投稿されたフリー写真素材・画像を掲載しております。JPEG形式の高解像度画像が無料でダウンロードできます。気に入った化学実験の写真素材・画像が見つかったら、写真をクリックして、無料ダウンロードページへお進み下さい。高品質なロイヤリティーフリー写真素材を無料でダウンロードしていただけます。商用利用もOKなので、ビジネス写真をチラシやポスター、WEBサイトなどの広告、ポストカードや年賀状などにもご利用いただけます。クレジット表記や許可も必要ありません。
写真素材リクエスト受け付け中
※100%対応はできませんが最大限努力をいたします。
無料で高品質な写真をダウンロードできます!加工や商用利用もOK!
無料ダウンロード会員登録はこちら